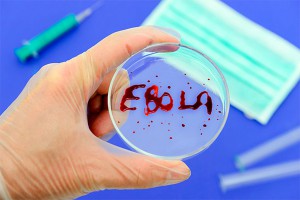
Ученые обвинили МВФ в эпидемии Эболы Ученые обвинили МВФ в эпидемии Эболы

10 октября, четверг | ![]() ![]() ![]() |
![]() | ПОЛИТИКА | ЭКОНОМИКА | ОБЩЕСТВО | ПРОИСШЕСТВИЯ | КУЛЬТУРА | СПОРТ | МЕДИА | В МИРЕ | АВТО | ТЕХНОЛОГИИ | ![]() |
| Фоторепортажи | Видеосюжеты | Комментарии | Погода | Работа | Форум | Карта | Подписка и RSS | Реклама| О газете |
Ученые обвинили МВФ в эпидемии Эболы22 декабря 2014, понедельник, 15:45 – БРЯНСК.RU | | Версия для печати Политические и экономические реформы, введенные МВФ, подорвали и без того хрупкий потенциал системы здравоохранения в странах Западной Африки. В итоге это вылилось в невозможность вовремя побороть вспышку лихорадки Эбола.Рассматривая реформы МВФ в период между 1990 и 2014 годами, исследователи выделили три их последствия. Первое: экономические реформы сократили государственные расходы, из-за чего пострадало финансирование медицины. Второе: Международный валютный фонд часто требует предела фонда заработной платы в государственном секторе, непосредственно влияя на способность этих стран нанять и адекватно оплачивать ключевых медицинских работников, таких как врачи и медсестры, что вылилось в их нехватку. И третье: МВФ выступает за децентрализованные системы здравоохранения, что на практике затруднило согласование мер и действий по устранению вспышек смертельных болезней, таких как лихорадка Эбола, пишет ТАСС со ссылкой на западные СМИ. Однако представители Фонда отвергают поступившие обвинения: "В минувшем месяце МВФ объявил о дополнительном финансировании на сумму почти 300 миллионов долларов работ по борьбе с вирусом Эбола в Гвинее, Либерии и Сьерра-Леоне". Отметим, что, по данным Всемирной организацией здравоохранения, число жертв болезни, вызванной вирусом Эбола, достигло 7373 человек, инфицированных – 1903. С 17 декабря в Гвинее, Либерии и Сьерра-Леоне число жертв болезни возросло почти на 500 человек. Источник:
|
![]() | ПОЛИТИКА | ЭКОНОМИКА | ОБЩЕСТВО | ПРОИСШЕСТВИЯ | КУЛЬТУРА | СПОРТ | МЕДИА | В МИРЕ | АВТО | ТЕХНОЛОГИИ | ![]() |
| Фоторепортажи | Видеосюжеты | Комментарии | Погода | Работа | Форум | Карта | Подписка и RSS | Реклама| О газете |
| Размещение рекламы в газете БРЯНСК.RU: Прайс-лист, тел. (4832) 37-19-38, почта info@briansk.ru Для информационных писем в редакцию: news@briansk.ru | ![]() | ![]() | ||
| 2005–2015 © Ежедневная интернет-газета БРЯНСК.RU При цитировании активная ссылка на БРЯНСК.RU обязательна Материалы газеты могут содержать информацию 18+ | ![]() | Открыв данный сайт, Вы соглашаетесь с Правилами cайта (договор-оферта). Если вы не согласны с Правилами, немедленно покиньте сайт! | ![]() |

В глубине экрана: Мастер-класс по ремонту телевизоров
Погружение в мир футбола онлайн: для поклонников Игры
Займ без проверок
Тотализаторы: что это такое и чем они отличаются от обычных ставок?
Играть в бесплатные игровые автоматы в онлайн-клубе Вулкан
Стоит ли посещать офтальмолога при замене очков?
Успешные игроки предпочитают игровые автоматы Вулкан
Новое казино Супер Слотс поможет воплотить ваши мечты в реальность







ПОПУЛЯРНЫЕ МАТЕРИАЛЫ










